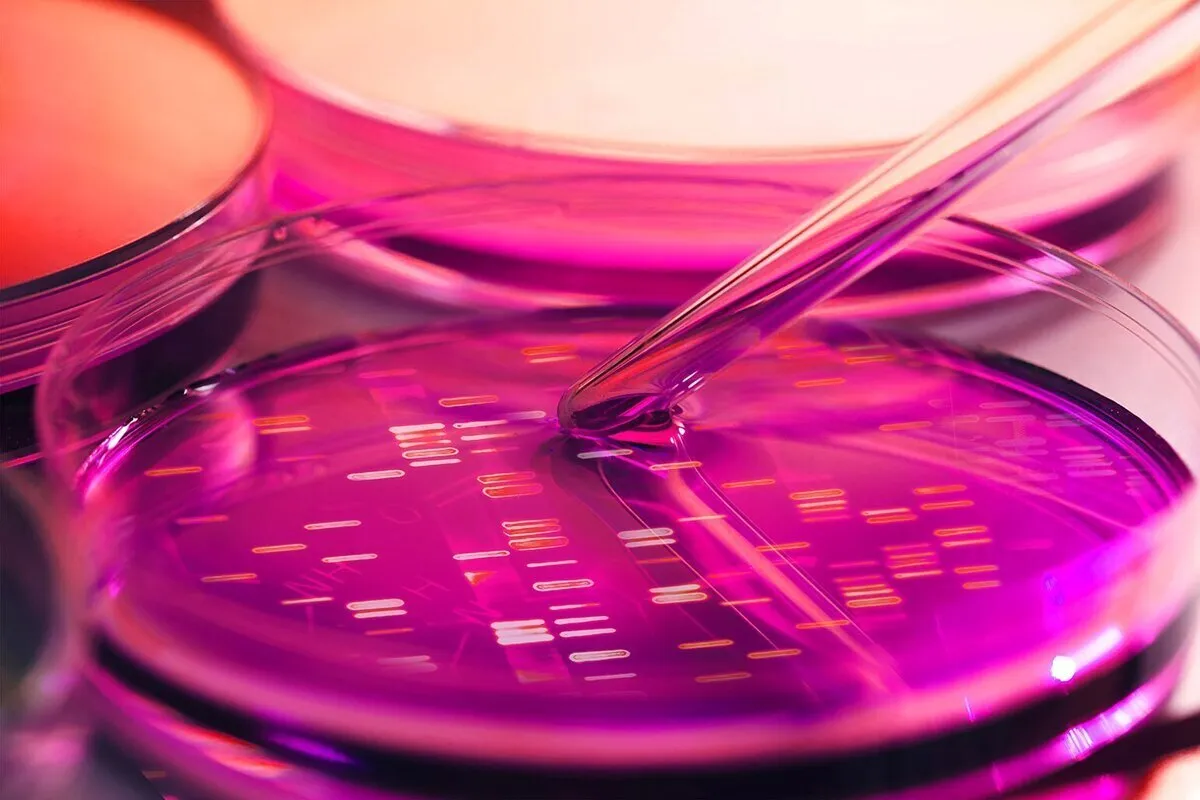

شركة ايرانية تصنّع محلول السلسلات الجينية "للوسيط FBF"
ووفقاً لوكالة آنا للعلوم والتكنولوجيا، قال مسعود عباسي المدير التنفيذي لمجموعة معرفية نشطة في مجال التكنولوجيا الحيوية والمعدات الطبية، في مقابلة مع وكالة آنا للعلوم والتكنولوجيا، حول الطبيعة الدقيقة لمنتج "الوسيط FBF": الوسيط الجيني FBF هو منتج يستخدم في جميع المختبرات الوراثية.
وأوضح عن وظيفة هذه السلسلة الجينية: ترتيب هذه السلسلة هو أنها توفر بيئة مناسبة لزراعة الجينات DNA و RNA. وفي الواقع، تعتبر هذه السلسلات بمثابة حل مختبري لتحضير العينات في المختبرات الوراثية.
وتحدث مدير الشركة المعرفية الايرانية عن خصائص وسعر العينة الأجنبية من هذا المحلول وتابع: سعر العينة الأجنبية من هذا المحلول حوالي 800 يورو لكل نصف لتر؛ لكن السعر النهائي للعينة المحلية يبلغ حوالي 300 ألف تومان (الدولار يعادل50 ألف تومان) لكل نصف لتر.
وذكر رئيس هذه المجموعة المعرفية أن جمهور هذا السلسلات الجينية هم في الغالب من المختبرات داخل البلاد وقال: إن حل المجموعة الجينية هذا مناسب لجميع المختبرات الجينية الجزيئية وبالطبع جميع الشركات التي تنتج أو تبيع هذه المجموعات من الجينات للمختبرات.
*أنابيب مختبر الحمض النووي للتليف الكيسي،
ولفت الرئيس التنفيذي لشركة المعرفة الناشطة في مجال التكنولوجيا الحيوية والمعدات الطبية إلى منتج معرفي آخر للشركة، وهو نتيجة تطوير قسم المعدات المخبرية في هذه الشركة، وتابع: أنابيب CF DNA هي من بين منتجات هذه الشركة الأخرى وهي عبارة أنابيب يتم من خلالها أخذ عينات من DNA و RNA من الأم والجنين في الأسبوع الـ 13 من الحمل أثناء أخذ عينة من الدم خلال شهرين ثم يتم الاحتفاظ بها في هذه الأنابيب.














